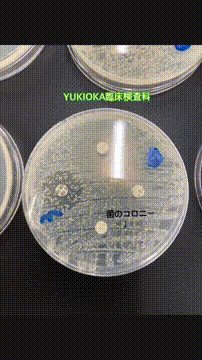
OCカメラサムネイル画像
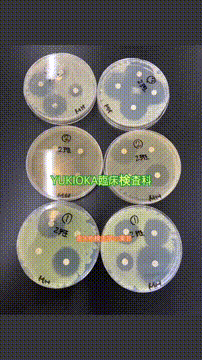
OCカメラサムネイル画像
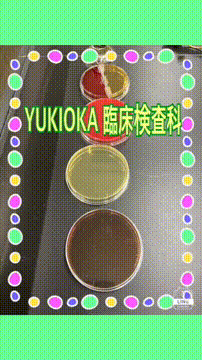
OCカメラサムネイル画像
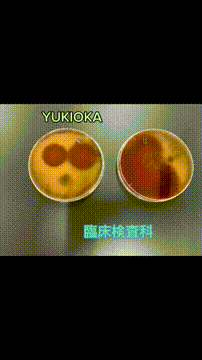
OCカメラサムネイル画像

大阪行岡医療専門学校長柄校
開催地と日程
OCストーリーズ
概要
大阪行岡医療専門学校長柄校の魅力がたっぷり詰まったオープンキャンパス!
ひとりで参加しても安心!教員・学生スタッフが優しくサポートします。
行岡保健衛生学園は、3校6学科を運営しております。
【内容】
・学校説明
※入試問題解説
・体験授業
・キャンパスツアー
・個別相談
保護者の方とご一緒に参加していただけます。
イベントの流れ
2部制のため、1日で2つの学科に参加できちゃう!
-

保護者の参加もOK! 受付からオープンキャンパス開始まで
受付は開始時間の30分前からになります。
午前、午後で違った学科に参加できます!
-

学校&学科説明
各学科の説明や入試問題の解説など
-

体験実習
学科の特徴がわかる体験実習で皆様をお待ちしております!
-

キャンパスツアー
各学科の実習施設や3科共有の図書室、売店をご紹介!
-

個別相談も実施中!
体験実習中でも教員や学生に学校生活や業界について質問できます!
スペシャルムービー






イベント一覧
オープンキャンパスに参加しよう!※イベントによっては予約も可能です。
-
学校に行ってみよう!学校開催
-
おうちで簡単に参加!オンライン開催
過去のイベント一覧
オープンキャンパスよくある質問例
- オープンキャンパスに行くときの服装は、
制服?私服? - 制服でも私服でもOK!
自分の動きやすい服装を選ぼう。
ただし訪問先に不快感を与えるような服装は
避けるように気をつけよう。 - 持ち物・服装を詳しくチェック
- オープンキャンパスの持ち物は?
- 筆記用具やメモ帳、学校の連絡先、
地図や路線図など事前に準備をしっかりしよう。
また携帯電話などは持って行ってもOKだけど、
授業や説明を聞くときはマナーモードにするか
電源を切ることを忘れずに! - 持ち物・服装を詳しくチェック
- オープンキャンパスのチェックポイントは?
- 進学や施設・設備、雰囲気や学ぶ内容、
取得できる資格や卒業後の進路など、
参加するオープンキャンパスが
「なんだか楽しいだけだった」なんてことに
ならないように、見学のポイントを押さえておこう。 - 見学当日のチェックポイント
- オープンキャンパスは一人でいっていいの?
親と行ってもいいの? - 約7割の人が友達と行っているみたいだけど、
保護者と一緒に参加している人も
年々増加しているみたい。
保護者にとっても、どんな学校かはやっぱり
気になるところ。
他の人は誰と行ったかチェックしてみよう。 - オープンキャンパス誰と行った?
オープンキャンパスがわかる!おすすめの記事特集

オープンキャンパスって何!?入学前に必ず行っておいた方がよい理由とは



【オープンキャンパス誰と行く?】


オープンキャンパスお役立ちガイド